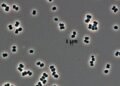
A bactéria descoberta pela NASA que pode "fingir-se de morta" e ter sido mandada sem querer para Marte

A detecção e o monitoramento de corpos celestes potencialmente perigosos continuam sendo prioridades para as principais agências espaciais. Por isso, o asteroide conhecido como 2024 YR4 chama atenção após recentes atualizações sobre seu risco de colisão com a Terra. O fato levou especialistas e entidades internacionais a intensificarem esforços de vigilância. Afinal, desde sua descoberta, em 2024, o acompanhamento de sua trajetória envolve procedimentos rigorosos de análise orbital e cálculos probabilísticos, essenciais para avaliar sua real ameaça ao planeta.
O acompanhamento de objetos próximos à Terra, conhecidos pela sigla NEOs, faz parte de uma rede global de vigilância. O 2024 YR4 integra essa classe, apresentando características que despertam interesse e preocupação. Especialistas alertam que, embora o risco de impacto tenha aumentado nos últimos relatórios, a previsão ainda aponta uma probabilidade relativamente baixa. No entanto, a incerteza motivou o reforço das observações, garantindo maior precisão nas informações disponíveis.

Quais são as dimensões e características do asteroide 2024 YR4?
O asteroide 2024 YR4 possui dimensões estimadas entre 40 e 100 metros de comprimento. Ele é comparável à altura de um edifício com aproximadamente 18 andares. Esse tamanho confere ao objeto capacidade de causar danos consideráveis caso atinja uma região habitada, embora não seja suficiente para provocar destruição em larga escala. Estudos apontam que asteroides dessa categoria podem gerar impacto regional significativo, afetando cidades ou áreas metropolitanas de grande densidade populacional.
Sua descoberta foi realizada pelo Sistema de Último Alerta para Impacto de Asteroides com a Terra, conhecido pela sigla ATLAS, um dos projetos dedicados a rastrear objetos espaciais que podem representar ameaça. Após a identificação, a avaliação sobre sua trajetória e potencial de risco sofreu reavaliações, com o percentual de chance de colisão sendo atualizado à medida que novas observações se consolidavam. Atualmente, a previsão para possível impacto está marcada para dezembro de 2032, o que colocou o objeto em alerta para monitoramento contínuo.
Como as agências espaciais monitoram riscos de colisão?
A atuação da NASA e da Agência Espacial Europeia envolve o uso conjunto de telescópios ópticos e sistemas de radar, tanto em solo quanto em órbita. O objetivo central dessas instituições é registrar, catalogar e rastrear movimentos de asteroides que cruzam a trajetória da Terra. No caso do 2024 YR4, observações priorizadas têm permitido ajustes nos cálculos da órbita e no dimensionamento dos riscos, além de possibilitar o estudo de possíveis técnicas de desvio.
Entre as estratégias de defesa planetária, destacam-se projetos experimentais voltados à alteração de rota de corpos menores, conhecidos como missões de deflexão de asteroides. Essas iniciativas estão em fase de teste, direcionadas sobretudo para objetos dentro da faixa de tamanho do 2024 YR4. A cooperação internacional também é um fator relevante, promovendo o intercâmbio de dados e técnicas para aumentar a capacidade de resposta em situações emergenciais.
O que significa o nível de risco do 2024 YR4 na escala de Torino?
A chamada escala de Torino foi criada para comunicar de forma eficiente o risco associado ao impacto de asteroides e cometas próximos à Terra. Essa classificação vai de 0, quando não há possibilidade de impacto previsto, até 10, que indica colisão inevitável com efeitos globais. O nível 3, ocupado atualmente pelo 2024 YR4, aponta para um cenário onde é necessário realizar um acompanhamento atento, mas ainda sem motivos para medidas de emergência imediata.
- Nível 0 a 1: Nenhuma chance relevante de colisão ou objetos extremamente pequenos.
- Nível 2 a 3: Necessidade de observação adicional devido à incerteza sobre a trajetória ou potencial de impacto regional.
- Níveis acima de 4: Riscos significativos e necessidade de preparação para ações preventivas, dependendo do contexto.
É importante ressaltar que a escala considera tanto a probabilidade quanto a energia do possível impacto, tornando a comunicação dos riscos mais clara para cientistas, tomadores de decisão e o público em geral. O nível do 2024 YR4, embora incomum, já trouxe o objeto para o radar prioritário das agências de monitoramento.

Por que o monitoramento de asteroides é essencial para a segurança?
O rastreamento regular de asteroides próximos da Terra contribui diretamente para prevenir desastres naturais relacionados a impactos de objetos espaciais. A detecção precoce permite uma janela de tempo mais ampla para análise e tomada de medidas preventivas, como evacuação de áreas de risco ou eventual ação para desviar o objeto em questão. Além disso, o estudo desses corpos fornece insumos importantes para a compreensão da história e da formação do Sistema Solar, enriquecendo o conhecimento científico sobre a origem dos planetas e das condições que favorecem a vida.
De forma geral, a vigilância contínua é vista como uma ferramenta indispensável diante das incertezas do espaço. A ciência avança no sentido de ampliar as capacidades tecnológicas de observação e resposta, ao mesmo tempo em que reforça a necessidade de colaboração internacional diante de obstáculos que ultrapassam fronteiras. Em 2025, a trajetória do 2024 YR4 permanece sob constante escrutínio, demonstrando a importância de uma postura atenta em relação aos desafios impostos pelo ambiente espacial.